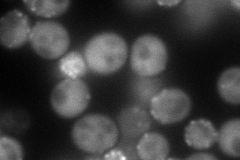
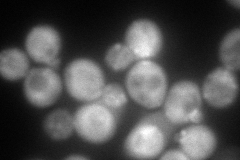
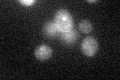

View description
Beta subunit of the capping protein (CP) heterodimer (Cap1p and Cap2p) which binds to the barbed ends of actin filaments preventing further polymerization; localized predominantly to cortical actin patches
Localization:
Intensity:
Fold change:
Significance:
-
C’ GFP library in SD

below threshold17.02 -
N' NOP1pr-GFP in SD
cytosol,punctate,bud144.919 -
N' TEF2pr-mCherry in SD
punctate,bud neck221.444 -
N' NATIVEpr-GFP in SD

punctate,bud neck31.5501 -
N' TEF2pr-VC and Cyto-VN in SD

punctate,bud neck46.105 -
C’ GFP library in SD+DTT
cytosol16.990.99No -
C’ GFP library in SD+H2O2

cytosol17.051No -
C’ GFP library in Starvation Media

cytosol16.060.94No -
C’ GFP library on the background of Pup2-DaMP

below threshold -
C’ GFP library on the background of CCT mutant

below threshold18.75481.10124No
